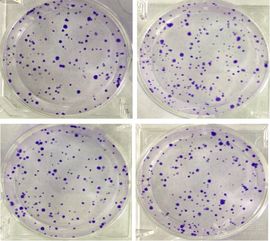
做細(xì)胞實(shí)驗(yàn)的方法有哪些

(1)顯微觀察法,如觀察植物細(xì)胞有絲分裂、觀察葉綠體和細(xì)胞質(zhì)流動(dòng)、觀察植物細(xì)胞質(zhì)壁分離和復(fù)原實(shí)驗(yàn)等.
(2)觀色法,如觀察動(dòng)物毛色和植物花色的遺傳等.
(3)原子示綜法,如噬菌體浸染細(xì)菌的實(shí)驗(yàn),用18O2和14CO2追蹤光合作用中氧原子和碳原子轉(zhuǎn)移途徑的實(shí)驗(yàn)等.
(4)等組實(shí)驗(yàn)法,如小麥淀粉酶催化淀粉水解的實(shí)驗(yàn),發(fā)現(xiàn)生長(zhǎng)素的燕麥胚芽鞘實(shí)驗(yàn)等.
(5)加法創(chuàng)意法,如用飼喂法研究甲狀腺激素,用注射法研究動(dòng)物胰島素和生長(zhǎng)激素,用移植法研究性激素等.
(6)減法創(chuàng)意法,如用閹割法、摘除法研究性激素、甲狀腺激素和生長(zhǎng)激素的實(shí)驗(yàn),雌蕊受粉后除去正在發(fā)育著的種子等.
(7)雜交實(shí)驗(yàn)法,如孟德?tīng)柊l(fā)現(xiàn)遺傳定律的植物雜交、測(cè)交的實(shí)驗(yàn),小麥的雜交等.
(8)化學(xué)分析法,如番茄和水稻對(duì)Ca和Si選擇性吸收,葉綠體中色素的提取和分離實(shí)驗(yàn)等.
(9)理論分析法,如大、小兩種草履蟲(chóng)競(jìng)爭(zhēng)的實(shí)驗(yàn),植物根向地生長(zhǎng)、莖背地生長(zhǎng)的實(shí)驗(yàn),植物向光性實(shí)驗(yàn)等.
(10)模擬實(shí)驗(yàn)法,如滲透作用的實(shí)驗(yàn)裝置,分離定律的模擬實(shí)驗(yàn)等
實(shí)驗(yàn)方法是整個(gè)實(shí)驗(yàn)設(shè)計(jì)的精髓,是做好實(shí)驗(yàn)設(shè)計(jì)的關(guān)鍵所在.現(xiàn)將與中學(xué)實(shí)驗(yàn)有關(guān)的一些最常見(jiàn)的經(jīng)典的實(shí)驗(yàn)方法匯總?cè)缦拢?/p>
(1)化學(xué)物質(zhì)的檢測(cè)方法:
①淀粉——碘液
②還原糖——斐林試劑、班氏試劑
③CO2——Ca(OH)2溶液或酸堿指示劑
④乳酸——pH試紙
⑤O2——余燼復(fù)燃
⑥無(wú)O2——火焰熄滅
⑦蛋白質(zhì)——雙縮脲試劑
⑧染色體——龍膽紫、醋酸洋紅溶液
⑨DNA——二苯胺試劑
⑩脂肪——蘇丹Ⅲ或蘇丹Ⅳ染液
(2)實(shí)驗(yàn)結(jié)果的顯示方法:
①光合速率——O2釋放量或CO2吸收量或淀粉產(chǎn)生量
②呼吸速率——O2吸收量或CO2釋放量或淀粉減少量
③原子途徑——放射性同位素示蹤法
④細(xì)胞液濃度大小——質(zhì)壁分離
⑤細(xì)胞是否死亡——質(zhì)壁分離
⑥甲狀腺激素作用——?jiǎng)游锖难趿?,發(fā)育速度等
⑦生長(zhǎng)激素作用——生長(zhǎng)速度(體重變化,身高變化)
⑧胰島素作用——?jiǎng)游锘顒?dòng)狀態(tài)
⑨菌量——菌落數(shù)或亞甲基藍(lán)溶液褪色程度
⑩大腸桿菌——伊紅—美藍(lán)瓊脂培養(yǎng)基
(3)實(shí)驗(yàn)條件的控制方法:
①增加水中氧氣——泵入空氣或吹氣或放入綠色植物
②減少水中氧氣——容器密封或油膜覆蓋或用涼開(kāi)水
③除去容器中CO2——NaOH溶液
④除去葉片中原有淀粉——置于黑暗環(huán)境
⑤除去葉片中葉綠素——酒精隔水加熱
⑥除去光合作用對(duì)呼吸作用的干擾——給植株遮光
⑦如何得到單色光——棱鏡色散或彩色薄膜濾光
⑧血液抗凝——加入檸檬酸鈉
⑨線粒體提取——細(xì)胞勻漿離心
⑩骨的脫鈣——鹽酸溶液
⑾滅菌方法——微生物培養(yǎng)的關(guān)鍵在于滅菌,對(duì)不同材料,滅菌方法不同:培養(yǎng)基用高壓蒸氣滅菌;接種環(huán)用火焰灼燒滅菌;雙手用肥皂洗凈,擦干后用75%酒精消毒;整個(gè)接種過(guò)程都在實(shí)驗(yàn)室無(wú)菌區(qū)進(jìn)行.
(4)實(shí)驗(yàn)中控制溫度的方法:
①還原糖鑒定:水浴煮沸加熱
②酶促反應(yīng):水浴保溫
③用酒精溶解葉中的葉綠素:酒精要隔水加熱
④DNA的鑒定:水浴煮沸加熱
⑤細(xì)胞和組織培養(yǎng)以及微生物培養(yǎng):恒溫培養(yǎng)
1.實(shí)驗(yàn)方法 實(shí)驗(yàn)方法是整個(gè)實(shí)驗(yàn)設(shè)計(jì)的精髓,是做好實(shí)驗(yàn)設(shè)計(jì)的關(guān)鍵所在。
現(xiàn)將與中學(xué)實(shí)驗(yàn)有關(guān)的一些最常見(jiàn)的經(jīng)典的實(shí)驗(yàn)方法匯總?cè)缦拢?(1)化學(xué)物質(zhì)的檢測(cè)方法: ①淀粉——碘液 ②還原糖——斐林試劑、班氏試劑 ③CO2——Ca(OH)2溶液或酸堿指示劑 ④乳酸——pH試紙 ⑤O2——余燼復(fù)燃 ⑥無(wú)O2——火焰熄滅 ⑦蛋白質(zhì)——雙縮脲試劑 ⑧染色體——龍膽紫、醋酸洋紅溶液 ⑨DNA——二苯胺試劑 ⑩脂肪——蘇丹Ⅲ或蘇丹Ⅳ染液 (2)實(shí)驗(yàn)結(jié)果的顯示方法: ①光合速率——O2釋放量或CO2吸收量或淀粉產(chǎn)生量 ②呼吸速率——O2吸收量或CO2釋放量或淀粉減少量 ③原子途徑——放射性同位素示蹤法 ④細(xì)胞液濃度大小——質(zhì)壁分離 ⑤細(xì)胞是否死亡——質(zhì)壁分離 ⑥甲狀腺激素作用——?jiǎng)游锖难趿?,發(fā)育速度等 ⑦生長(zhǎng)激素作用——生長(zhǎng)速度(體重變化,身高變化) ⑧胰島素作用——?jiǎng)游锘顒?dòng)狀態(tài) ⑨菌量——菌落數(shù)或亞甲基藍(lán)溶液褪色程度 ⑩大腸桿菌——伊紅—美藍(lán)瓊脂培養(yǎng)基 (3)實(shí)驗(yàn)條件的控制方法: ①增加水中氧氣——泵入空氣或吹氣或放入綠色植物 ②減少水中氧氣——容器密封或油膜覆蓋或用涼開(kāi)水 ③除去容器中CO2——NaOH溶液 ④除去葉片中原有淀粉——置于黑暗環(huán)境 ⑤除去葉片中葉綠素——酒精隔水加熱 ⑥除去光合作用對(duì)呼吸作用的干擾——給植株遮光 ⑦如何得到單色光——棱鏡色散或彩色薄膜濾光 ⑧血液抗凝——加入檸檬酸鈉 ⑨線粒體提取——細(xì)胞勻漿離心 ⑩骨的脫鈣——鹽酸溶液 ⑾滅菌方法——微生物培養(yǎng)的關(guān)鍵在于滅菌,對(duì)不同材料,滅菌方法不同:培養(yǎng)基用高壓蒸氣滅菌;接種環(huán)用火焰灼燒滅菌;雙手用肥皂洗凈,擦干后用75%酒精消毒;整個(gè)接種過(guò)程都在實(shí)驗(yàn)室無(wú)菌區(qū)進(jìn)行。 (4)實(shí)驗(yàn)中控制溫度的方法: ①還原糖鑒定:水浴煮沸加熱 ②酶促反應(yīng):水浴保溫 ③用酒精溶解葉中的葉綠素:酒精要隔水加熱 ④DNA的鑒定:水浴煮沸加熱 ⑤細(xì)胞和組織培養(yǎng)以及微生物培養(yǎng):恒溫培養(yǎng) 2.斐林試劑、班氏試劑與尿糖試紙 這三種物質(zhì)均可用來(lái)檢驗(yàn)含醛基的有機(jī)物的存在,在醫(yī)學(xué)上用來(lái)檢驗(yàn)糖尿病,其原理均是利用了Cu2+的氧化性把醛基氧化,但成分略有不同: 斐林試劑:即硫酸銅、氫氧化鈉和酒石酸鉀鈉組成的藍(lán)色混合溶液。
分為斐林試劑A和斐林試劑B,A為CuSO4溶液,B為氫氧化鈉和酒石酸鉀鈉的混合溶液,使用時(shí)將A、B等體積混合即成斐林試劑。 班氏試劑:即硫酸銅、碳酸鈉和檸檬酸鈉組成的混合液,又叫本尼迪克特(Benedict)試劑,它與醛反應(yīng)的結(jié)果是與斐林試劑一致的,只是比斐林試劑更穩(wěn)定,所以在臨床化驗(yàn)中更常使用。
尿糖試紙:又叫硫酸銅試紙,呈白色,帶藍(lán)色斑點(diǎn),用于糖尿病患者的尿糖測(cè)試。每片含硫酸銅20毫克,枸櫞酸300毫克,碳酸鈉80毫克,氫氧化鈉235毫克。
尿糖試紙法快速、方便,試紙的正確使用方法為:將試紙條放在尿液中浸濕,一秒鐘后取出,在一分鐘內(nèi)觀察試紙的顏色,并與標(biāo)準(zhǔn)色板對(duì)照,根據(jù)不同的顏色來(lái)確定尿糖陽(yáng)性的程度。 3.斐林試劑和雙縮脲試劑的比較 相同點(diǎn):①都由NaOH溶液和CuSO4溶液構(gòu)成; ②斐林試劑甲液和雙縮脲試劑A都為0.1g/mLNaOH溶液。
不同點(diǎn):①CuSO4溶液濃度不一樣:斐林試劑乙液為0.05g/mLCuSO4溶液, 雙縮脲試劑B為0.01g/mLCuSO4溶液。 ②配制比例不一樣。
③使用方法不一樣:斐林試劑是甲、乙液一起混合后再使用, 雙縮脲試劑則是先向待鑒定材料加入A試劑搖勻后,再加入試劑B。 ④鑒定的對(duì)象不一樣:斐林試劑鑒定的是還原糖,雙縮脲試劑鑒定的是蛋白質(zhì)。
⑤反應(yīng)本質(zhì)及顏色反應(yīng)不一樣。 4.蘇丹Ⅲ染液與蘇丹Ⅳ染液的比較 都是用來(lái)鑒定脂肪。
蘇丹Ⅳ染液更易溶于脂肪,所以染色更深,同時(shí)要求染色時(shí)間更短。 生物學(xué)中常用的試劑: 1、斐林試劑: 成分:0.1g/ml NaOH(甲液)和0.05g/ml CuSO4(乙液)。
用法:將斐林試劑甲液和乙液等體積混合,再將混合后的斐林試劑倒入待測(cè)液,水浴加熱或直接加熱,如待測(cè)液中存在還原糖,則呈磚紅色。 2、班氏糖定性試劑:為藍(lán)色溶液。
和葡萄糖混合后沸水浴會(huì)出現(xiàn)磚紅色沉淀。用于尿糖的測(cè)定。
3、雙縮脲試劑:成分:0.1g/ml NaOH(甲液)和0.01g/ml CuSO4(乙液)。用法:向待測(cè)液中先加入2ml甲液,搖勻,再向其中加入3~4滴乙液,搖勻。
如待測(cè)中存在蛋白質(zhì),則呈現(xiàn)紫色。 4、蘇丹Ⅲ:用法:取蘇丹Ⅲ顆粒溶于95%的酒精中,搖勻。
用于檢測(cè)脂肪??蓪⒅救境砷冱S色(被蘇丹Ⅳ染成紅色)。
5、二苯胺:用于鑒定DNA。DNA遇二苯胺(沸水?。?huì)被染成藍(lán)色。
6、甲基綠:用于鑒定DNA。DNA遇甲基綠(常溫)會(huì)被染成藍(lán)綠色。
(甲基綠使DNA呈現(xiàn)綠色,吡羅紅使RNA呈現(xiàn)紅色。) 7、50%的酒精溶液:在脂肪鑒定中,用蘇丹Ⅲ染液染色,再用50%的酒精溶液洗去浮色。
8、75%的酒精溶液:用于殺菌消毒,75%的酒精能滲入細(xì)胞內(nèi),使蛋白質(zhì)凝固變性。低于這個(gè)濃度,酒精的滲透脫水作用減弱,殺菌力不強(qiáng);而高于這個(gè)濃度,則會(huì)使細(xì)菌表面蛋白質(zhì)迅速脫水,凝固成膜,妨礙酒精透入,削弱殺菌能力。
75%的酒精溶液常用于手術(shù)前、打針、換藥、針灸前皮膚脫碘消毒以及機(jī)。
1.顯微觀察法:如“觀察細(xì)胞有絲分裂”“觀察葉綠體和細(xì)胞質(zhì)流動(dòng)”“用顯微鏡觀察多種多樣的細(xì)胞”等.
2.觀色法:如“生物組織中還原糖、脂肪和蛋白質(zhì)的鑒定”“觀察動(dòng)物毛色和植物花色的遺傳”“DNA和RNA的分布”等.
3.同位素標(biāo)記法(元素示蹤法):如“噬菌體浸染細(xì)菌的實(shí)驗(yàn)”“恩格爾曼實(shí)驗(yàn)”等.
4.補(bǔ)充法:如用飼喂法研究甲狀腺激素,用注射法研究動(dòng)物胰島素和生長(zhǎng)激素,用移植法研究性激素等.
5.摘除法:如用“閹割法、摘除法研究性激素、甲狀腺激素或生長(zhǎng)激素的作用”“雌蕊受粉后除去正在發(fā)育著的種子”等.
6.雜交法:如植物的雜交、測(cè)交實(shí)驗(yàn)等.
7.化學(xué)分析法:如“番茄對(duì)Ca和Si的選擇吸收”“葉綠體中色素的提取和分離”等.
8.理論分析法:如“大、小兩種草履蟲(chóng)的競(jìng)爭(zhēng)實(shí)驗(yàn)”“植物向性動(dòng)物的研究”等.
9.模擬實(shí)驗(yàn)法:如“滲透作用的實(shí)驗(yàn)裝置”“分離定律的模擬實(shí)驗(yàn)”等.
10.引流法:臨時(shí)裝片中液體的更換,用吸水紙?jiān)谝粋?cè)吸引,于另一側(cè)滴加換進(jìn)的液體.
細(xì)胞固定化方法有:Adsorption(吸附);covalent bonding(共價(jià)結(jié)合);Cross linking(交聯(lián));Entrapment(包埋)、Encapsulation(微膠囊) 。下面對(duì)這幾種做具體介紹。
一、吸附法
1,原理
利用載體和細(xì)胞表面所帶電荷的靜電引力(van der Walls forces),使細(xì)胞吸附于載體上。吸附法可分為物理吸附和離子吸附兩種。該法操作簡(jiǎn)單,固定化過(guò)程對(duì)細(xì)胞活性影響小。
2,載體的材料
采用吸附法固定細(xì)胞,所用的載體主要有:硅藻土、木屑、多孔玻璃、活性炭、
多孔陶瓷、離子交換樹(shù)脂和等。塑料
3,影響吸附固定化的因素
(1)Z-電位
(2)細(xì)胞的性質(zhì)和細(xì)胞壁的組成
(3)載體的性質(zhì)
(4)pH
二、共價(jià)結(jié)合法
利用細(xì)胞表面的反應(yīng)基團(tuán)(如氨基、羧基、羥基、巰基、咪唑基)與活化的無(wú)機(jī)或有機(jī)載體反應(yīng),形成共價(jià)鍵將細(xì)胞固定。用該法制備的固定化細(xì)胞一般為死細(xì)胞。
三、交聯(lián)法
利用雙功能或多功能試劑與細(xì)胞表面的反應(yīng)基團(tuán)(如氨基、羧基、羥基、巰基、咪唑基)反應(yīng),從而使細(xì)胞固定。常用的交聯(lián)劑包括:戊二醛、甲苯二異氰酸酯、雙重氮聯(lián)苯胺。
由于交聯(lián)試劑的毒性,這一方法具有一定的局限性。
四、包埋法
包埋法是細(xì)胞固定化最常用的方法。包埋法可以分為:
1,微膠囊法:利用半透性聚合物薄膜將細(xì)胞包裹起來(lái),形成微型膠囊;
2,凝膠包埋法:是在無(wú)菌條件下,將生物細(xì)胞和膠溶液混合在一起,然后再經(jīng)過(guò)相應(yīng)的造粒處理,形成直徑為1-4mm的膠粒。
常用的包埋劑為:聚丙烯酰胺、瓊脂、海藻酸、卡拉膠、二醋酸纖維、三醋酸纖維、明膠等。
五、固定化方法的比較
吸附法:條件溫和、方法簡(jiǎn)便、載體可再生。但操作穩(wěn)定性差。
共價(jià)法:操作穩(wěn)定性高。但由于試劑的毒性,易引起細(xì)胞的破壞。
交聯(lián)法:可得到高細(xì)胞濃度,但機(jī)械強(qiáng)度低,無(wú)法再生,不適于實(shí)際應(yīng)用。
包埋法:細(xì)胞和載體間沒(méi)有束縛,固定化后,細(xì)胞仍保持較高活力。但這類(lèi)方法只適用于小分子底物。
細(xì)胞生物學(xué)的研究方法: 1. 顯微成像包括直接成像和間接成像。
顯微技術(shù)是細(xì)胞生物學(xué)最基本的研究技術(shù), 包括光學(xué)顯微技術(shù)和電子顯微技術(shù)。在光學(xué)顯微技術(shù)中要掌握幾種常用顯微鏡成像的基本原理,包括普通雙筒顯微鏡、熒光顯微鏡、相差顯微鏡、暗視野顯微鏡、倒置顯微鏡。
2. 細(xì)胞化學(xué)技術(shù):酶細(xì)胞化學(xué)技術(shù)、免疫細(xì)胞化學(xué)技術(shù)、細(xì)胞分選技術(shù), 其中流式細(xì)胞分選技術(shù)是細(xì)胞生物學(xué)和現(xiàn)代生物技術(shù)中的重要技術(shù)。 3. 細(xì)胞工程技術(shù)是細(xì)胞生物學(xué)與遺傳學(xué)的交叉領(lǐng)域,主要利用細(xì)胞生物學(xué)的原理和方法,結(jié)合工程學(xué)的技術(shù)手段,按照人們預(yù)先的設(shè)計(jì),有計(jì)劃地改變或創(chuàng)造細(xì)胞遺傳性的技術(shù)。
包括體外大量培養(yǎng)和繁殖細(xì)胞,或獲得細(xì)胞產(chǎn)品、或利用細(xì)胞體本身。主要內(nèi)容包括:細(xì)胞融合、細(xì)胞生物反應(yīng)器、染色體轉(zhuǎn)移、細(xì)胞器移植、基因轉(zhuǎn)移、細(xì)胞及組織培養(yǎng)。
4. 分離技術(shù)是一大類(lèi)技術(shù)的總稱(chēng),包括細(xì)胞組分的分離和生物大分子的分離, 。 5.分子生物學(xué)方法。
一、實(shí)驗(yàn)準(zhǔn)備
(一)材料:長(zhǎng)得較粗壯的幼苗,蘿卜條或馬鈴薯?xiàng)l。
(二)用品:燒杯,試管,清水,鹽水。
二、方法步驟
(一)取兩塊蘿卜條或馬鈴薯?xiàng)l,分別放人盛有清水和鹽水的燒杯中浸泡,過(guò)一段時(shí)間取出,可見(jiàn)清水中的蘿卜條硬挺,而鹽水中的蘿卜條則軟縮。這表明植物細(xì)胞可以吸水,也可以失水,并且吸水和失水與環(huán)境中溶液的濃度有關(guān)系。應(yīng)注意此實(shí)驗(yàn)最好是在課前做好,或在上一節(jié)課時(shí)布置給學(xué)生。實(shí)驗(yàn)過(guò)程需要約20min。
(二)此實(shí)驗(yàn)也可用兩株植物幼苗,分別將它們的根部插在盛有清水和鹽水(或糖水)的兩個(gè)試管內(nèi),大約20min左右,從試管里取出兩棵幼苗進(jìn)行比較,可見(jiàn)清水中的幼苗硬挺,而鹽水(或糖水)中的幼苗則萎蔫了。這同樣可以證明植物細(xì)胞可以吸水,也可以失水。此實(shí)驗(yàn)同時(shí)還說(shuō)明了土壤溶液濃度過(guò)大或施肥過(guò)量影響根吸收水分的道理。
三、教學(xué)建議
植物細(xì)胞吸水實(shí)驗(yàn)既是教材中《根對(duì)水分的吸收》一節(jié)的演示實(shí)驗(yàn),又是這一節(jié)課的引言。本實(shí)驗(yàn)大約需要20min左右的時(shí)間。因此,可以發(fā)動(dòng)學(xué)生在課前自己用生活中常用的器皿開(kāi)展實(shí)驗(yàn),然后拿到課堂上演示。在演示時(shí),應(yīng)在實(shí)驗(yàn)材料的后面加一張白紙作為背景,以便使學(xué)生能觀察清楚。
只找到一份
根據(jù)每個(gè)細(xì)胞有一定的重量而設(shè)計(jì)的。
它可以用于單細(xì)胞、多細(xì)胞以及絲狀體微生物生長(zhǎng)的測(cè)定。將一定體積的樣品通過(guò)離心或過(guò)濾將菌體分離出來(lái),經(jīng)洗滌,再離心后直接稱(chēng)重,求出濕重,如果是絲狀體微生物,過(guò)濾后用濾紙吸去菌絲之間的自由水,再稱(chēng)重求出濕重。
不論是細(xì)菌樣品還是絲狀菌樣品,可以將它們放在已知重量的平皿或燒杯內(nèi),于105℃烘干至恒重,取出放入干燥器內(nèi)冷卻,再稱(chēng)量,求出微生物干重。如果要測(cè)定固體培養(yǎng)基上生長(zhǎng)的放線菌或絲狀真菌,可先加熱至50℃,使瓊脂熔化,過(guò)濾得菌絲體,再用50℃的生理鹽水洗滌菌絲,然后按上述方法求出菌絲體的濕重或干重。
除了干重、濕重反映細(xì)胞物質(zhì)重量外,還可以通過(guò)測(cè)定細(xì)胞中蛋白質(zhì)或DNA的含量反映細(xì)胞物質(zhì)的量。蛋白質(zhì)是細(xì)胞的主要成分,含量也比較穩(wěn)定,其中氮是蛋白質(zhì)的重要組成元素。
從一定體積的樣品中分離出細(xì)胞,洗滌后,按凱氏定氮法測(cè)出總氮量。蛋白質(zhì)含氮量為16%,細(xì)菌中蛋白質(zhì)含量占細(xì)菌固形物的50%一80%,一般以65%為代表,有些細(xì)菌則只占13%一14%,這種變化是由菌齡和培養(yǎng)條件不同所產(chǎn)生的。
因此總含氮量與蛋白質(zhì)總量之間的關(guān)系可按下列公式計(jì)算:蛋白質(zhì)總量=含氮量*6.25核酸DNA是微生物的重要遺傳物質(zhì),每個(gè)細(xì)菌的DNA含量相當(dāng)恒定,平均為8.4*`10^(-5)`NG。因此從一定體積的細(xì)菌懸液中所含的細(xì)菌中提取DNA,求得DNA含量,再計(jì)算出這一定體積的細(xì)菌懸液所含的細(xì)菌總數(shù)。
聲明:本網(wǎng)站尊重并保護(hù)知識(shí)產(chǎn)權(quán),根據(jù)《信息網(wǎng)絡(luò)傳播權(quán)保護(hù)條例》,如果我們轉(zhuǎn)載的作品侵犯了您的權(quán)利,請(qǐng)?jiān)谝粋€(gè)月內(nèi)通知我們,我們會(huì)及時(shí)刪除。
蜀ICP備2020033479號(hào)-4 Copyright ? 2016 學(xué)習(xí)鳥(niǎo). 頁(yè)面生成時(shí)間:2.647秒